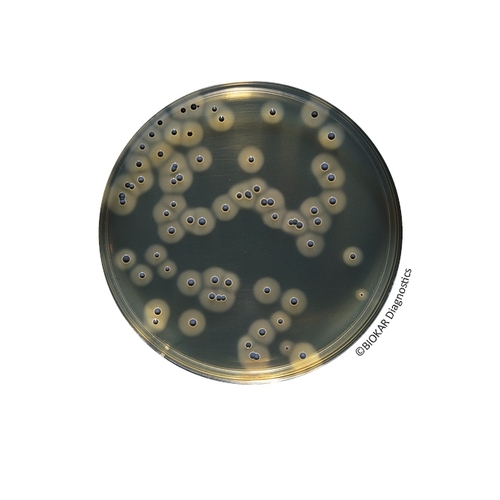
Baird Parker RPF Agar

| Ürün Adı |
Rabbit Plasma Fibrinogen (RPF) Supplement |
| Ürün Kodu |
BS03808 |
| Miktar |
1 vial qsp 500 mL |
| Ürün Adı |
Rabbit Plasma Fibrinogen (RPF) Supplement |
| Ürün Kodu |
BS03408 |
| Miktar |
8 vials qsp 100 mL |
| Ürün Adı |
Baird Parker RPF Agar |
| Ürün Kodu |
BK055GC |
| Miktar |
5 kg |
| Ürün Adı |
Baird Parker RPF Agar |
| Ürün Kodu |
BK055HA |
| Miktar |
500 g |
| Ürün Adı |
Baird Parker RPF Agar |
| Ürün Kodu |
BT01008 |
| Miktar |
6 vials of 190 mL + 6 RPF Supplements |
| Ürün Adı |
Baird Parker RPF Agar |
| Ürün Kodu |
BT00508 |
| Miktar |
6 vials of 90 mL + 6 RPF Supplements |
| Ürün Adı |
Baird Parker RPF Agar |
| Ürün Kodu |
BM15908 |
| Miktar |
20 Petri plates Ø 55 mm |
| Ürün Adı |
Baird Parker RPF Agar |
| Ürün Kodu |
BM06708 |
| Miktar |
20 Petri plates Ø 90 mm |